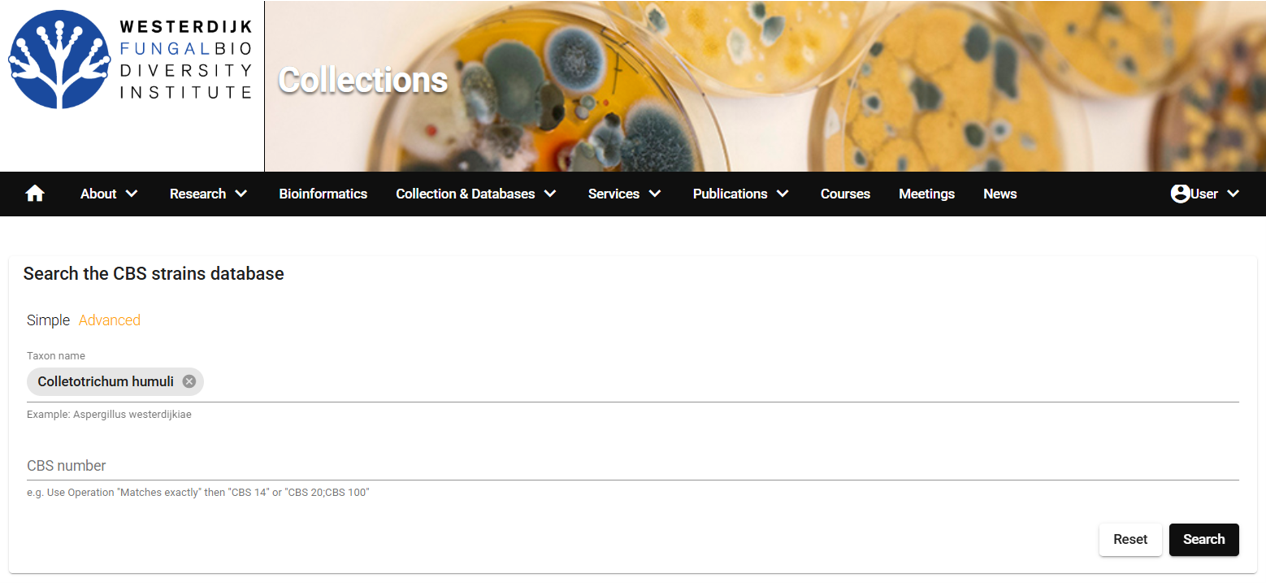
그림-Westerdijk.png

뜻밖의 논문, 135년전 곰팡이 유전자 염기서열 해독
시시콜콜한 곰팡이 분류 논문 이야기
인생이 계획적이었든가?
친구따라 강남간다고 친구가 농진청에 발령받아 가는 것을 보고 7월에 공부하기 시작해서 11월에 시험보고 농진청에 입사하게 되었다. 처음에는 벼유전체연구실에 발령받았지만 일하는 것이 시원찮아서였든지 다음 해에 신설된 미생물분류실로 이동 배치되었다.
대학교 2학년 1학기 때에 미생물학을 수강하였으나 공부를 못해서 과락을 받았다. 미생물학은 전공필수인지라 3학년 1학기에 다시 도전하였는데 그때는 산에 다니느라 정신이 팔려 또다시 과락을 받았다.
결국 군대에를 갔었고 복학하여 울며 겨자먹기로 다시 미생물학을 수강신청하려 하는데, 미생물학이 전공필수에서 선택으로 바뀌었단다. 물론 수강하지 않았다. 결국 재수를 하고도 이수하지 못한 과목이 미생물학인데, 그 미생물 연구를 발령받은 다음 해부터 해야 했고 지금까지 32년째 하고 있다.
인생이 계획적이길 바라는 것은 과한 욕심이다. 돌이켜보면 철저하게 계획하고 한 실험 결과가 꼭 좋지는 않았고, 생각지도 못한 곳에서 좋은 결과가 나와 그것들이 나의 대표적인 성과가 되어 버렸다.
최근에 Nature의 자매지라고 하는 Scientific Report에 탄저병균 분류 논문이 하나실렸는데 이 역시 우연의 산물이라 소개해 보고자 한다.
탄저병 곰팡이 연구
 고추탄저병(온라인 한국식물병명목록 https://genebank.rda.go.kr/kplantdisease.do 유래)
고추탄저병(온라인 한국식물병명목록 https://genebank.rda.go.kr/kplantdisease.do 유래)이야기의 시작은 2020년으로 거슬러 올라간다. 이웃의 전북대학교 최효림 학생이 학부의 마지막 학기를 우리 연구실에서 실습으로 보냈다. 그런데 효림씨가 일도 잘하고 호흡도 잘 맞기에 결국 우리 실험실에서 석사과정을 하게 되었다.
우리 연구실은 농업미생물은행(KACC)을 운영한다. 농업미생물은행이 농업미생물을 관리하는 은행이니 다양한 미생물을 보유하고 있다. 그중에는 작물에 병을 내어 곡식 생산에 문제를 일으키는 식물병 곰팡이도 많다. 대표적인 곰팡이들이 도열병균, 역병균, 시들음병균, 탄저병균 등이다.
우리나라에는 세계적으로 유명한 식물병 사냥꾼이 계신다. 고려대학교에 재직하셨던 신현동 교수님인데 논밭의 작물뿐만이 아니라 산야를 다니면서 다양한 식물에 병을 일으키는 곰팡이를 모으신다. 교수님은 박사학위로 흰가루병을 하셨지만 흰가루병외에도 도열병, 점무늬병, 탄저병균 등 식물에 병을 일으키는 대부분의 곰팡이를 사냥하신다.
2000년 전까지는 곰팡이 병을 발견하고는 병든 식물체를 건조하여(허바리움, hebarium) 보관하였다. 하지만 2000년 이후에는 식물건조표본을 보관할 뿐만이 아니라, 원인 병원 미생물을 분리하여 농업미생물은행(KACC)에 기탁하셨다.
식물의 탄저병은 사람에게 치명적인 병을 일으키는 세균의 탄저병과 이름이 같은데다가 고추와 사과 같은 경제작물에 큰 피해를 끼치기에 많은 사람들로부터 주목을 받고 있다.
 과수 탄저병에 관한 농촌진흥청 현수막
과수 탄저병에 관한 농촌진흥청 현수막
따라서 농업미생물은행(KACC)도 탄저병 곰팡이를 많이 확보하고 있다. KACC가 설립된 1995년부터 도입한 고추의 탄저병균, 그리고 사과시험장에서 온 사과의 탄저병균, 그리고 신현동 교수님이 야외의 식물에서 분리하여 기탁한 탄저병균 등 2021년 당시에 한국에서 분리된 약 400균주의 탄저병 균주를 가지고 있었다.
 농업미생물은행(KACC) 미생물 검색 페이지
농업미생물은행(KACC) 미생물 검색 페이지시간이 지나면 기술이 발전하고 기술이 발전하면 미생물의 분류 체계가 바뀐다. KACC가 1995년부터 탄저병균을 모으기 시작했는데 이미 30여년의 시간이 흘렀으니, 그 사이에 탄저병균의 분류 체계도 얼마나 많이 변했겠는가? 30년전부터 도입되어 KACC에 보관되어 온 탄저병 균주들이, 오래된 이름 말고 현재에 맞는 새이름을 붙여 달라고 아우성치는 것 같았다.
이러한 때에 마침 효림씨가 농업미생물은행에서 석사를 하게 된 것이다. 효림씨는 당연하게 한국산 탄저병균에 대한 재분류 연구를 하게 되었다. 효림씨는 그간 보관되어 있던 탄저병 곰팡이를 깨워서 다시 배양하고 분석하기 시작하였다.
곰팡이 분류는 여러 가지 방법이 있는데 2000년 이전에는 곰팡이를 배양기에 배양 후에 콜로니 모양을 본다거나 현미경을 이용하여 포자 형태를 관찰하는 등의 형태적 방법이 주를 이루었다. 하지만 21세기가 되어 분자생물학이 발달하면서는 곰팡이 분류도 유전자 분석이 더 중요하게 되었다. 특히 곰팡이의 분류용 유전자들의 염기서열을 분석하여 비교하는 다수유전자염기서열비교법(MLST)이 곰팡이 분류의 핵심 수단이 되었다.
사용하는 유전자는 곰팡이에 따라 조금은 다르지만 탄저병균은 rDNA-ITS, GAPDH, TUB2, CHS-1, HIS3, ACT 유전자가 주로 사용되었다. 즉 종(種, species)을 모르는 탄저병균의 종을 밝혀내기 위해서는(동정, 同定, identification) 해당 곰팡이의 위의 유전자 염기서열을 분석한 후에 이미 알려져 있는 종의 유전자들과 비교하여 유전자들의 염기서열이 서로 같으면 같은 종이고 서로 다르면 다른 종이 되는 것이다(여기서 유전자가 모두 100% 같으면 쉽게 동정이 되지만, 조금 다를 경우에는 이것이 같은 종인지 다른종인지를 판단하는 데는 전문가적인 판단이 필요하다).
다행히 탄저병균은 독일의 Ulike Damm 그룹과 중국의 Liu F. 그룹이 기존에 알려진 탄저병 종들에 대하여 위의 유전자 염기서열을 잘 모아서 정리해 놓은 상태였다.
많은 탄저병 균주에 대하여 다수의 유전자의 염기서열을 해독한다는 것은 쉬운 일이 아니다. 효림씨는 우선 위의 6개의 유전자 중에서 더욱 중요하게 사용되는 rDNA-ITS, GAPDH, TUB2 유전자의 염기서열을 해독하고 KACC가 보유한 탄저병균을 동정해 나갔다. 대부분의 탄저병균 유전자 염기서열이 기존에 보고된 종의 유전자 염기서열과 일치하여 현재의 분류 체계에 맞는 종의 이름을 다시 붙여 줄 수 있었다.
그런데 기존에 보고된 종과는 세 개의 유전자가 매우 다른 균주들이 나타났다. 환삼덩굴에서 분리된 4 균주는 기존에 보고된 어떤 종과도 많이 다른 염기서열을 가지고 있었다.
환삼덩굴 탄저병 연구 시작, 그러나 답을 찾을 수 없었다.
동정(균주의 종명을 밝히는 작업)이 어려운 종을 만나게 되면 미생물 초보자와 전문가의 입장이 달라진다. 초보자는 답을 찾기 어려워지니 이를 곤란하게 받아들인다. 하지만 전문가는 답을 찾기가 어려운 만큼 논문의 좋은 주제가 됨을 알고 더욱 흥미를 느끼게 된다.
환삼덩굴에서 분리된 탄저병균이 기존에 보고된 어떤 종과도 염기서열이 다르다는 것은 이것이 기존에 보고된 종이 아닌 새로운 종일 가능성이 매우 크다는 것이다. 우리는 기쁜 마음으로 신종에 대한 기대를 가지고 이 균주를 처음 분리하여 농업미생물은행에 기탁한 신현동 교수님을 찾았다.
신현동 교수님께서도 환삼덩굴에서 분리한 탄저병균이 형태적으로 다른 탄저병균과 매우 달라서 신종일 가능성이 높다고 생각했다라고 말씀하셨다. 그런데 우려되는 것은 환삼덩굴과 자매 관계에 있는 홉의 탄저병균이 보고가 되어 있으므로 환삼덩굴탄저병균이 신종임을 밝히기 위해서는 홉탄저병균과 다름을 입증해야 한다는 말씀을 주셨다.
식물병을 연구하기 위해서는 그 식물에 관하여 먼저 공부를 해야한다. 잠깐 탄저병이 발생한 환삼덩굴과 그 자매 종인 홉에 대하여 알아보고 가자.
환삼덩굴(Humulus scandense (이명, Humulus japonicus), wild hop)은 이름만 들어서는 모를 수도 있으나 식물체 사진을 보면 누구나 알 수 있는 한국에서 매우 흔한 식물이다.
 햇볕 잘드는 곳에는 지천으로 자라는 환삼덩굴. 이 글을 쓰려고 전주의 완산도서관엘 갔는데 도서관 주차장의 차를 주차하는 곳까지 환삼덩굴이 침범했다.
햇볕 잘드는 곳에는 지천으로 자라는 환삼덩굴. 이 글을 쓰려고 전주의 완산도서관엘 갔는데 도서관 주차장의 차를 주차하는 곳까지 환삼덩굴이 침범했다. 길가, 들. 빈터 등에서 흔하게 자라며 줄기에 가시가 있고 다른 식물 위를 뒤덮고 자란다. 다른 식물의 생장에 피해를 줌으로 우리나라에서는 생태계 교란 야생식물로 정해져 있다. 환삼덩굴은 한국, 일본, 중국 등의 동아시아 원산인데 최근에 북미와 유럽에 도입되어 문제를 발생시켜 침입종(invasive species)로 지정되었다. 특히 유럽연합 국가로의 도입, 재배 등이 금지되어 있다.
따라서 환삼덩굴 탄저병 연구는 분류학적으로도 중요하지만 이들을 효과적으로 방제하기 위한 생물학적 방제 측면에서도 매우 중요하다.
반면에 홉(Humulus lupulus, Common hop)은 대부분 본 적은 없지만 익숙한 이름이다. 홉의 암꽃이 맥주 제조의 주재료로 쓰이기 때문에 우리는 생맥주, 생맥주집을 호프, 호프집으로 부른다(홉 또는 호프로 발음되나 국립국어원의 정식 표기는 홉이다). 홉은 유럽원산으로 여러해살이 덩굴풀로서 야생에는 흔치 않고 주로 재배된다. 우리나라에도 일부 재배되고 있다
 홉(Humulus lupulus, Common hop, 위키피디아 사진)
홉(Humulus lupulus, Common hop, 위키피디아 사진)향기를 내고 적당한 쓴맛을 주어 맥주의 주재료로 쓰이는 홉이, 가시가 있고 아무데나 자라며 다른 식물의 생장을 방해하는 환삼덩굴과 가까운 자매지간이라는 것이 믿기지 않으나 이들은 삼과의 환삼덩굴(Humulus)속에 속하며 종소명만이 다른 매우 가까운 사이다.
환삼덩굴 신종여부를 가리기 위하여 홉의 탄저병균(Colletotrichum humuli)에 대하여 조사하기 시작했다.
이 균에 대한 분류용 유전자 염기서열을 찾으면 일은 쉽게 해결된다. 환삼덩굴탄저병균 유전자 염기서열은 우리가 이미 해독해서 가지고 있으니 홉 탄저병 유전자 염기서열이 있다면 비교해서 서로 같은지 다른지만 보면 된다.
하지만 홉탄저병균의 염기서열은 어디에도 보고된 적이 없다. 있었다면 전임 연구자인 네덜란드의 Damm이나 중국의 Liu가 먼저 챙겼겠지?
다음으로 홉탄저병균의 살아있는 배양체를 조사했다. 배양체를 구할 수 있으면 이를 키워서 유전자 염기서열을 해독하면 된다. 세계미생물은행연맹(WFCC)과 곰팡이의 대표적인 은행 WI, 등의 미생물은행을 뒤졌으나 배양체를 보유한 곳을 찾을 수가 없었다.
 네덜란드 Westerdijk Institute . 여기에서도 홉탄저병 균주를 보유하고 있지 않다.
네덜란드 Westerdijk Institute . 여기에서도 홉탄저병 균주를 보유하고 있지 않다.
그 다음은 건조표본이다. Mycology Collections Portal을 뒤졌더니 다행히도 홉 탄저병에 대한 식물건조표본이 22개나 보관이 되어 있었다. 주로 미국과 캐나다의 식물표본 보관소에 보존되어 있었다.
 균학 허바리움 포털
균학 허바리움 포털하지만 이들을 미국이나 캐나다에서 들여오기도 어렵지만 들여온들 형태적 특징이나 서로 비교할 텐데. 그래봐야 형태적 특징으로는 환삼덩굴탄저병균과 홉탄저병균을 어차피 구분하기는 어려울 것이다.
신현동 교수님은 이미 홉탄저병균을 처음 보고한 원문을 확보하고 계셨는데, 불행하게도 환삼덩굴탄저병균의 형태적 특징은 호프탄저병균의 그것과 크게 다르지 않아 서로 구분되지 않았다.
더는 진행하기가 어려웠다. 게다가 효림씨는 석사 졸업 논문을 마무리해야 해서 이것만을 붙잡고 있을 상황이 되지 못했다. 그래서 할 수 없이 효림씨의 석사논문에는 환삼덩굴탄저병균은 홉탄저병균과 형태적으로 서로 구분이 어렵고, 두 식물은 자매 종이므로 환삼덩굴탄저병균은 홉탄저병균과 같은 종인 Colletotrichum humulus일 것이라고 하고 일단 마무리하였다.
구원투수의 등장
농촌진흥청은 세계 개발도상국가의 연구자들을 위한 장기연수프로그램을 운영하고 있다. 여기에 탄저병균 분류를 포함한 농업미생물은행 운영 과제를 응모하였는데 다행스럽게도 선정되어 베트남의 젊은 연구자를 지원받게 되었다.
효림씨가 졸업하고 난 이후에 더 이상 탄저병균 연구를 할 수 없었는데, 다시 탄저병 연구를 할 좋은 기회였다. 베트남의 국가 식물보호연구소에 근무하는 Le Dinh Thao는 곰팡이 분류에 많은 경험을 가지고 있었다. 일본의 오사카대학에서 곰팡이 분류로 석사를 하였으며 세계 균학자들과 교류하며 공동의 논문을 발표한 적이 있었다.
좋은 실험 재료에 이미 효림씨가 많은 데이터를 만들어 놓은 상황이어서 Thao씨는 그 결과를 정리하여 좋은 논문으로 발표할 수 있었다. 상대적으로 논란이 없는 것들에 대하여 먼저 정리해서 논문을 게재하고 여유가 생기자, 결국 제대로 마무리하지 못하여 미련이 남아았는 환삼덩굴 탄저병과 마주하게 되었다.
이번에는 정면으로 승부를 해보고자 하였다. 홉탄저병균 건조표본이 그래도 북미의 식물표본소에 저장되어 있으니 이것을 도입해서 형태도 관찰해 보고 혹시 유전자 염기서열 해독이 되는지 시도라도 해보자는 것이었다.
북미 식물표본소로부터 홉탄저병균 건조표본 도입은 배양으로 증식이 불가한 표본이라 분양받기가 쉽지 않을 것으로 생각했다. 그런데 의외로 쉽게 그것도 무상으로 미시간주립대 균류표본소(Michigan State University Herbarium non-lichenized fungi, MSC)로부터 분양 받았다(나는 시간적인 여유가 없었고 Thao씨가 균류표본소와 이메일을 몇 번 주고 받더니 건조표본 실물이 미국에서 왔다.). 우편으로 배달된 홉 탄저병 시료는 달랑 홉 잎 세 조각이었다.

분양받은 건조표본은 135년전인 1890년도에 만들어진 것이지만 상태가 양호하였다. 먼저 현미경으로 표본을 조심스럽게 관찰한 결과 홉 탄저병 균주의 포자는 환삼덩굴 포자에 비하여 조금 더 짧고 가늘었다. 그리고 환삼덩굴 균주의 포자가 끝부분이 뭉턱한 반면에 홉 탄저병 균주는 끝부분이 뾰족하여 서로 구분된다는 느낌이었다. 하지만 모든 포자가 그런 것은 아니어서 명확히 서로 구분된다고 할 수는 없었다.
 홉 탄저병(C. humuli)의 형태적 특징(Scientific Reports, 2025: 15:26560)
홉 탄저병(C. humuli)의 형태적 특징(Scientific Reports, 2025: 15:26560)결국 두 균주가 같은 종인지 다른 종인지는 분류용 유전자 염기서열을 해보아야 확실히 결론을 내릴 수 있었다.
135년 된 홉 탄저병 건조표본으로부터 탄저병 곰팡이 유전자 염기서열 해독과 논문 게재
분류용 유전자 염기서열 해독을 위하여 식물체표본으로부터 탄저병균 포자덩어리를 수확하였다. 식물체가 따라오지 않도록 그리고 다른 곰팡이가 묻지 않도록 해부 현미경하에서 조심스럽게 이루어졌다. 그 이후에 전체 DNA를 추출하였다. 직접 배양한 것에서 전체 DNA를 추출하는 방법에 비하여 초기 incubation 시간을 더 길게 하였을 뿐 큰 차이는 없었다.
추출된 전체 DNA로부터 rDNA ITS를 증폭하기 위하여 일반적으로 사용되는 ITS1/ITS4 프라이머를 사용하였으나 증폭되지 않았다. 이번에는 ITS 영역을 둘로 나누어 ITS1영역과 ITS2 영역으로 나누어 증폭하였다. 예상대로 원하는 밴드를 얻을 수 있었다. 이는 오래된 표본이라 탄저병균 DNA가 깨어져서 500bp 이상인 전체 ITS는 증폭이 불가하였고 이를 300bp 미만으로 나누었을 때(ITS1, ITS2 각각)에 증폭이 가능하였다.
하지만 증폭된 영역에 대하여 염기서열 분석을 실시하였을 때는 여러 중복된 피크가 발생하여 읽을 수가 없었다. 즉 원하는 탄저병 균주 외에도 오염된 다른 곰팡이가 함께 증폭되어 있었다. 오염된 곰팡이를 빼고 홉 탄저병 균주만을 증폭할 필요가 있었다.
따라서 홉에서 보고된 다른 곰팡이들 (Phomatodes, Alternaria, Phaeomycocentrospora, Ascochyta 등)과는 구분되는 홉탄저병균만을 증폭할 수 있는프라이머를 디자인하였다(ITSCF1). ITSCF1과 기존의 ITS4를 이용하여 ITS2영역을 증폭할 수 있었다. 그리고 이들 프라이머를 이용하여 염기서열 분석하였을 때에 오염되지 않은 깔끔한 염기서열 피크를 얻을 수 있었다.
드디어 홉 탄저병 균주의 ITS 영역의 염기서열을 확보하였으니 이제 환삼덩굴 탄저병 균주와 비교반 해보면 이들이 같은 종인지 다른 종인지를 알 수가 있다. 두근대는 가슴을 안고 서로 비교해 본 결과, 두 균주의 염기서열 상동성은 96.5%였다. 같은 종이라고 하기에는 차이가 많았지만 그렇다고 완전히 다른 종이라고 하기도 애매한 수치였다.
rDNA ITS 염기서열을 어렵게 확보한 후라서, 다른 유전자들은 비교적 쉽게 분류용 유전자 염기서열을 확보할 수 있었다. GAPDH, CHS-1, HIS3, ACT 유전자의 염기서열을 확보하였는데 GAPDH의 경우에는 홉탄저병균주와 환삼덩굴탄저병 균주의 상동성이 77.5%로 매우 낮았다. 결국 이들은 명확히 다른 종임이 입증되었다.
 홉 탄저병 균주 MSC0211749는 아래의 환삼덩굴 탄저병 5균주와는 유연관계가 멀어 둘은 서로 다른종으로 결정났다(Scientific Reports, 2025, 15:26)
홉 탄저병 균주 MSC0211749는 아래의 환삼덩굴 탄저병 5균주와는 유연관계가 멀어 둘은 서로 다른종으로 결정났다(Scientific Reports, 2025, 15:26)2006년에 환삼덩굴에서 분리되어 농업미생물은행에 보관되었된 탄저병 균주는 2021년에 다시 연구를 시작하여 4년만에 Colletotrichum humulicola라는 이름으로 세계에 알려지게 되었다.
흥미로운 홉 탄저병 건조표본 스토리
환삼덩굴 탄저병 균주가 어렵게 자기 이름을 얻게 되었지만, 홉 탄저병 균주 역시 어렵게 자기 자리를 지킬 수 있게 되었다.
현재 곰팡이 분류에서 가장 핵심이 되는 수단은 다수유전자염기서열비교법(MLST, Multilocus Sequence Typing)이다. 즉 분류용 유전자들을 분석하여 이들이 서로 같으면 한 종이고 서로 다르면 다른종이다. 따라서 특정의 종은 rDNA ITS 등의 분류용 유전자에 대한 특정 염기서열을 가진다.
따라서 분류용 유전자의 염기서열을 갖지 못한 종은 이용되지 못하고 결국 사라지고 만다. 그런데 이번 실험에서 홉 탄저병의 분류용 유전자의 염기서열을 확보함으로써 홉탄저병균, Colletotrichum humuli의 위치가 명확하게 되었다.
C. humuli는 1929년에 처음 보고되었고 1944년까지는 보고되다가 그 이후로는 문헌이나 건조표본을 찾을 수가 없다. 대신에 2023년에 미국의 미시간주에서 홉에서 Colletotrichum fioriniae가 새로이 보고되었다. 따라서 본 실험을 통하여 C. humuli의 분류용 유전자 염기서열이 확보되지 않았다면 1900년대 초반에 보고되고 이후로는 자취를 감춘 C. humuli는 잘못된 보고로 취급되어 사라질 수 있는 상황이었다.
홉탄저병균(Colletotrichum humuli)도 기구한 팔자를 가지고 있다.
스토리는 May Varney라는 캔사스주립대의 농과대학 여학생으로부터 시작된다. 그녀는 1890년 5월에 미국 캔사스주의 맨하탄(Manhattan)의 홉 재배지에서 탄저병에 걸린 홉을 채집을 한다. 그리고 6월에 홉탄저병균이라고 라벨을 하고 건조표본으로 보관한다. 1년 뒤에 그녀는 미국 농무성에 취업하는데 이때에 그녀는 채집한 홉 탄저병 표본을 미농무성 건조표본소 (BPI)로 옮긴다.
 미농무성 진균표본소 홉탄저병 건조표본. Mycoportal (https://www.mycoportal.org/portal/)
미농무성 진균표본소 홉탄저병 건조표본. Mycoportal (https://www.mycoportal.org/portal/)그리고는 BPI뿐만이 아니라 당시의 유명한 미국과 캐나다의 건조 표본소인 코넬대, 미시간대, 브리티시콜롬비아대 등의 대학보존소와 뉴욕식물원, 캐나다국가진균표본소(Canadian National Mycological Herbarium, DAOM) 등에 분산 보존한다. 그녀는 표본에 Colletotrichum humuli라고 곰팡이 이름까지 작명하여 표기하였으나 학계에 정식으로 보고하지는 않았다.
30여년 후 1929년에 캐나다의 국가진균표본소(DAOM)에 근무하던 균학자 John Dearness는 May Varney가 1890년에 보내온 건조표본을 근거로 하여 Colletotrichum humuli Dearn.라는 이름으로 홉 탄저병을 처음으로 학계에 공식적으로 보고한다.
명명자가 May Varney가 아닌 John Dearness인 이유도 May가 처음 수집하였을지라도 보고를 John이 했기 때문이다. 그리고 John Dearness는 신종을 보고할 때에 본인이 소속된 DAOM에 있는 표본을 가지고 종을 기술하였기에 정기준표본(holotype)은 DAOM 18043이 되었다. May Varney가 수집하여 처음 보관하였던 미농무성의 BPI 864716의 건조표본이 오히려 동기준표본(Isotyep)이 되었다.
 캐나다 DAOM의 홉 탄저병 균주, 135년전 표본인데도 완벽하게 관리되고 있다. 부럽다. (Mycoportal)
캐나다 DAOM의 홉 탄저병 균주, 135년전 표본인데도 완벽하게 관리되고 있다. 부럽다. (Mycoportal)
May Varney가 수집하여 미시간 주립대의 건조표본소(Michigan State University Herbarium non-lichenized fungi)에 보내진 표본이, 그리고 다시 100년 후에 한국으로 보내줘 Colletotrichum humuli의 분류용 유전자 염기서열 분석하는데 쓰이게 되었다.
 미시간대학 곰팡이 표본 보존소의 건조표본이 이번 실험에 사용되었다. 친절하게도 표본을 제공해준 미시간대에 감사드립니다. (Mycoportal)
미시간대학 곰팡이 표본 보존소의 건조표본이 이번 실험에 사용되었다. 친절하게도 표본을 제공해준 미시간대에 감사드립니다. (Mycoportal)135년전인 1890년에 한 여대생이 탄저병에 걸린 홉을 채집하여 Colletotrichum humuli라고 써 놓고 보관했는데, 이것이 30여년 후에 캐나다 균학자에 의하여 신종으로 보고되고, 다시 100년이 지나 한국으로 와서 분류용 염기서열이 분석됨으로써 안정적인 지위를 획득하게 되었다. 처음 채집하여 이름을 붙인 여대생 May Varney는 이미 현 세상에 사람은 아닐진대 아마도 다른 세상에서 이를 보고는 기뻐하고 있지 않을까?
환삼덩굴 탄저병을 계획하였으나 홉 탄저병이 주인공이 되었다.
원래 이 실험의 주제는 우리나라 환삼덩굴에 탄저병을 일으키는 균주가 신종인지를 확인하고 보고하는 것이었다. 그러나 환삼덩굴과 자매 관계에 있는 홉 탄저병을 분석하는 과정에서 홉 탄저병 표본이 135년 전 것이라 이 표본에서 rDNA ITS를 포함한 분류용 염기서열 분석하는 것에 더 관심을 가지게 되었다.
식물건조표본으로부터 탄저병 분류 유전자의 분석은 기존에 가장 오래된 것이 1915년 것이었다. 그것도 추출된 DNA를 바로 염기서열 분석한 것이 아니라 클로닝 단계를 거친 후에 분석한 것이었다. 본 실험에서 건조표본으로부터 탄저병 포자덩어리만을 모으고, 탄저병에 특이적인 ITSCF1이라는 프라이머를 디자인함으로써 가장 오래된 표본으로부터 손쉽게 탄저병 분류용 유전자 염기서열을 해독할 수 있었다.
그래서 논문도 일반 곰팡이 분류를 다루는 균학회지에 보고한 것이 아니라 조금 더 인용도가 높은 네이처 사에서 운영하는 Scientific Reports에 게재되었다. 논문과 별도로 오래된 식물건조표본으로부터 유전자 염기서열 해독 방법은 네이처사의 프로토콜 관리 플랫폼인 Protocols.io에 별도로 게재되었다.
 오래된 건조표본에서 곰팡이 유전자 염기서열 해독법의 실험 방법 게재
오래된 건조표본에서 곰팡이 유전자 염기서열 해독법의 실험 방법 게재
환삼덩굴 신종보고가 목적이었는데 이것은 부가 되고 135년전의 식물건조 표본으로부터 홉 탄저병 균주의 분류용 염기서열 해독한 것이 오히려 주가 된 것이다.
새로운 문제를 남기고......,
결국 환삼덩굴의 탄저병균은 홉탄저병균과는 서로 다른 지금까지 보고되지 않은 신종, Coletotrichum humulicola로 보고되었다. 그런데 C. humulicola 의 종기술 그림을 보면 이상한 점이 있다. 환삼덩굴에서 분리하였고 병을 낸다면 일반적으로 병징 사진이 종 기술에 포함되어야 한다. 그런데 종 기술 사진에 병징 사진이 없다.
 Colletotrichum humulicola 신종 기술(Scientific Reports, 2025, 15:26560)
Colletotrichum humulicola 신종 기술(Scientific Reports, 2025, 15:26560)여기에는 다음과 같은 사연이 있다.
식물병의 세계적인 사냥꾼 신현동 교수님은 2006년과 2007년에 환삼덩굴에서 분리한 4 균주의 탄저병 균주가 환삼덩굴에 주요 병원균이라고 했다. 그래서 이 병원균을 이용하여 한국에서 생태계교란종, 미국과 유럽에서 침입종(Invasive species)인 환삼덩굴을 생물학적으로 방제할 수 있는 좋은 재료가 될 것이라고 했다.
환삼덩굴탄저병원균이 홉탄저병원균가 유전자 수준에서 서로 다르다는 것을 확인하고는 Colletotrichum humulicola라고 이름을 지은 다음에 특징을 기술하고 보고하고자 하였다. 보고 전에 마지막으로 이 균주의 환삼덩굴에 대한 병원성을 검사하였다.
그런데 타오씨가 환삼덩굴 잎에 C. humulicola 균주를 아무리 접종해도 병이 발생하지 않는 것이었다. 그래서 2006,7년도에 수집되어 20여년간 보관되면서 병원성이 상실되었수도 있겠다 하여 이 균을 새로이 채집하였다. 하지만 새로이 구리 한강공원에서 수집한 환삼덩굴 탄저병 균주(KACC 410871)도 역시 환삼덩굴에서 병을 발생시키지 못하였다.
우리가 환삼덩굴 탄저병균인 C. humulicola에 관심을 가진 가장 큰 이유 중의 하나는 이 균이 대부분의 환삼덩굴 군락지에서 발병하고 병원력도 강하므로 이 균을 이용하여 환삼덩굴을 생물학적으로 방제해보고자 함이었다.
그래서 4년에 걸쳐 실험하고 미국에서 식물건조표본까지 들여와서 염기서열을 분석하여 서로 다름을 입증하고 분류학적으로 신종으로 보고를 했는데 이 균이 환삼덩굴에 병을 일으키는 균이 아니었다니???. 우리가 지금까지 환삼덩굴탄저병균이라고 계속 이야기 해 왔는데 이 이름마저 바꿔야 하나???
결국, 환삼덩굴의 생물학적 방제를 염두해 두고 환삼덩굴탄저병균의 분류연구를 시작했는데, 그 과정에서 예상치 못했던 135년된 홉 탄저병 건조표본으로부터 유전자 염기서열 해독 방법을 첫번째 주요 결과로 얻고, 환삼덩굴 신종보고는 두번째 결과로 얻고, 원래 바라던 환삼덩굴의 생물적 방제는 전혀 기대를 하기 어려운 상황이 되었다.
내 연구 인생도 그랬던 것 같다. 아스페곰팡이(Aspergillus) 분류 연구가 주목적이었는데, 분류 과정에서 디자인한 칼모듈린(calmodulin) 유전자 증폭용 프라이머가 관심을 받게 되고, 프라이머를 디자인한 논문이 내 논문 중에는 가장 많이 인용되었다. 그리고 메주의 검은누룩곰팡이(Aspergillus luchuensis)를 연구하다가 비교하기 위하여 사용했던 막걸리의 흰누룩곰팡이가 더 관심을 받게되어, 후자의 논문이 내가 가장 아끼는 논문이 되었다.
꼭 연구만 그런 것도 아니고, 친구따라 농진청 시험본 덕분에 32년째 근무를 하고 있고, 이게 내 인생의 대부분이 된 것이다.
인생 뭐 있나?
C. humulicola가 환삼덩굴에 병을 내지 못하는 것이 아닐 것이다. 세계적인 식물병 곰팡이 사냥꾼 신현동 교수님의 판단이 잘못되지 않았을 것이다. 이 균이 분명히 병을 강하게 내는데 병을 발생시키는 조건이 다르든지 무슨 이유가 있을 것이다.
아마도 이 이유를 밝히면 이 또한 좋은 논문이 되지 않을까?
환삼덩굴 탄저병 사진(KACC 43036, 신현동 교수님 촬영 및 채집)
환삼덩굴 탄저병 사진(KACC 43036, 신현동 교수님 촬영 및 채집)P.S.) 환삼덩굴 탄저병과 홉 탄저병 관련 이야기를 정리하면서 꼼꼼하게 지도하지도 못했는데도 스스로 열심히 하여 좋은 결과를 내준 최효림, Le Dinh Thao 학생에게 깊은 감사의 마음을 전합니다.